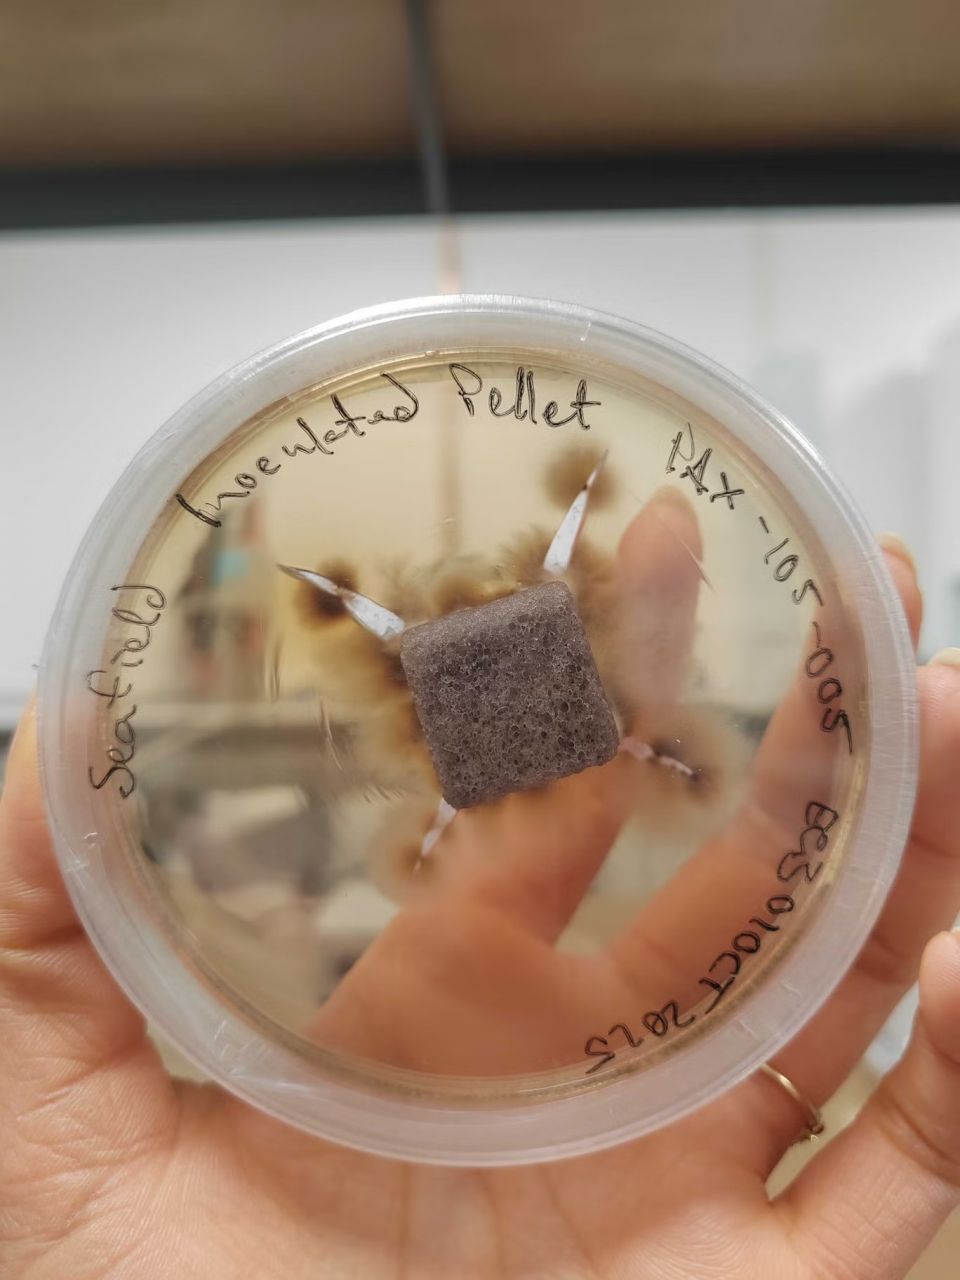
fungus-pellet.jpg

Πώς οι «υπερδυνάμεις» των μανιταριών αναγεννούν τα δάση σε όλο τον κόσμο
Μια πρωτοποριακή μέθοδο αναγέννησης δασών αναπτύσσει μια σκωτσέζικη εταιρεία, αξιοποιώντας τις «υπερδυνάμεις» των μυκήτων για να ενισχύσει την επιβίωση και την ανάπτυξη των δέντρων.
Η Rhizocore Technologies πειραματίζεται με ειδικά κατασκευασμένα πέλετ μανιταριών, τα οποία έχουν σχεδιαστεί για να υποστηρίζουν προγράμματα αναδάσωσης σε εδάφη όπου οι απαραίτητοι μικροοργανισμοί απουσιάζουν ή έχουν υποβαθμιστεί.
Όπως αναφέρει ο Independent, η εταιρεία δημιουργεί τη μεγαλύτερη βιβλιοθήκη μυκητιακών δειγμάτων στον κόσμο, συλλέγοντας μύκητες από διάφορες περιοχές του πλανήτη. Το αποτέλεσμα αυτής της έρευνας είναι μικρά, ορθογώνια, γκρι πέλετ που φυτεύονται μαζί με τα δενδρύλλια και έχουν στόχο να ενισχύσουν το έδαφος στο οποίο αναπτύσσονται.
Μια κρίσιμη συμβιωτική σχέση
Οι επιστήμονες της Rhizocore εξηγούν ότι τα δέντρα χρειάζονται ένα δίκτυο μυκορριζικών μυκήτων γύρω από τις ρίζες τους για να ευδοκιμήσουν. Πρόκειται για μια κρίσιμη συμβιωτική σχέση: οι μύκητες βοηθούν στην απορρόφηση νερού και θρεπτικών στοιχείων, ενώ τα δέντρα τούς παρέχουν ενέργεια. Η αποψίλωση δασών, η εντατική γεωργία και άλλες ανθρώπινες δραστηριότητες μπορούν να καταστρέψουν αυτούς τους μύκητες στο έδαφος, εμποδίζοντας τη φυσική αναγέννηση των δασών.
Ένα από τα μυκητιακά πέλετ της Rhizocore που τοποθετούνται στις ρίζες των δέντρων
Rhizocore TechnologiesΤα πέλετ μανιταριών τοποθετούνται δίπλα στα νεαρά δέντρα και ενισχύουν το ριζικό τους σύστημα καθώς αυτά μεγαλώνουν. Κάθε πέλετ περιέχει συγκεκριμένο τύπο μυκητιακής καλλιέργειας, προσαρμοσμένο στις ανάγκες του εκάστοτε δέντρου και στις τοπικές εδαφικές συνθήκες. Σύμφωνα με την εταιρεία, η χρήση τους μπορεί να αυξήσει τα ποσοστά επιβίωσης των δέντρων έως και κατά 50%. Σε πρόσφατο πρόγραμμα με την Υπηρεσία Δασών και Γης της Σκωτίας (Forestry and Land Scotland) καταγράφηκε σχετική βελτίωση της τάξης του 25%.
Μόνο το 10% των μυκήτων έχει καταγραφεί
Στις εγκαταστάσεις της Rhizocore κοντά στο Εδιμβούργο, χιλιάδες πέλετ παράγονται μέσω μιας προσεκτικά ελεγχόμενης διαδικασίας που περιλαμβάνει την «ζύμωση» συγκεκριμένων μυκήτων. Τα δείγματα συλλέγονται και αναλύονται σε εργαστηριακά σκεύη, ενώ ορισμένα φυλάσσονται σε κρυογονικό καταψύκτη, στους -80 βαθμούς Κελσίου. Όταν εντοπιστεί ο κατάλληλος μύκητας, παρασκευάζεται σε υγρή μορφή και εφαρμόζεται στα σφαιρίδια.
«Τα αποτελέσματά μας δείχνουν σαφώς ότι η επιτυχία της φύτευσης μπορεί να αυξηθεί αξιοποιώντας τις υπερδυνάμεις των μυκήτων στην υπόγεια λίπανση», δήλωσε ο ιδρυτής της εταιρείας, Δρ. Toby Parkes.
Όπως ανέφερε, παγκοσμίως υπάρχουν έως και τρία εκατομμύρια είδη μυκήτων, από τα οποία έχει καταγραφεί μόλις το 10%.
Τα σφαιρίδια της Rhizocore χρησιμοποιούνται ήδη σε αναδασώσεις και εμπορική δασοκομία στο Ηνωμένο Βασίλειο και την Ευρώπη. Η επιστήμονας δεδομένων φυτών της εταιρείας, Δρ. Petra Guy, επισημαίνει ότι πολλές αναδασώσεις γίνονται σε πρώην αγροτικά εδάφη ή σε ορεινές περιοχές όπου δεν υπήρχαν δέντρα για δεκαετίες ή και αιώνες, με αποτέλεσμα οι απαραίτητοι μύκητες να έχουν εξαφανιστεί. Το έργο της επικεντρώνεται στην εύρεση του κατάλληλου μύκητα για το κατάλληλο δέντρο, μια διαδικασία που περιλαμβάνει, όπως λέει, «ιδιαίτερα ευχάριστη» αναζήτηση στο ίδιο το έδαφος.
ΣΧΕΤΙΚΕΣ ΕΙΔΗΣΕΙΣ
Πόσο υγιή είναι τα ελληνικά δάση - Δορυφορικά δεδομένα του ΑΠΘ δίνουν την απάντηση
Ένας μύκητας που αναπτύσσεται στο Τσερνόμπιλ απέκτησε μια μοναδική ιδιότητα
Αισιόδοξα μηνύματα για το δάσος Αμαζονίου: Επέστρεψαν οι βροχές, μειώθηκαν 65% οι καμένες εκτάσεις
Ο μύκητας «κατάρα της μούμιας» μπορεί να αποτελέσει φάρμακο κατά του καρκίνου σύμφωνα με μελέτη
SPONSORED
Θεσσαλονίκη: Συναγερμός για φωτιά σε παραποτάμια έκταση του Αξιού
14:26
Πάτρα: Θανατηφόρο τροχαίο με θύμα 20χρονο οδηγό μηχανής - Σε κρίσιμη κατάσταση 46χρονος συνεπιβάτης
14:19
Ο Τομ Σέλεκ αναλαμβάνει ρόλο παρουσιαστή και παραγωγού σε νέα σειρά για το έγκλημα στις ΗΠΑ
14:10
Μήνυμα Ιράν σε ΗΠΑ μετά την νέα πρόταση Τραμπ: Καμία συμφωνία αν δεν διασφαλιστούν τα δικαιώματά μας
14:00